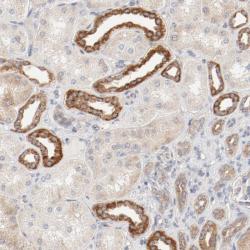

Antibody data
- Antibody Data
- Antigen structure
- References [2]
- Comments [0]
- Validations
- Western blot [1]
- Immunohistochemistry [1]
Submit
Validation data
Reference
Comment
Report error
- Product number
- sc-8044 - Provider product page

- Provider
- Santa Cruz Biotechnology
- Proper citation
- Santa Cruz Biotechnology Cat#sc-8044, RRID:AB_626717
- Product name
- Anti-BAD
- Antibody type
- Monoclonal
- Antigen
- Recombinant full-length protein
- Reactivity
- Human
- Host
- Mouse
Submitted references Identification of novel in vivo phosphorylation sites of the human proapoptotic protein BAD: pore-forming activity of BAD is regulated by phosphorylation.
Diffuse large B-cell lymphomas with germinal center B-cell-like differentiation immunophenotypic profile are associated with high apoptotic index, high expression of the proapoptotic proteins bax, bak and bid and low expression of the antiapoptotic protein bcl-xl
Polzien L, Baljuls A, Rennefahrt UEE, Fischer A, Schmitz W, Zahedi RP, Sickmann A, Metz R, Albert S, Benz R, Hekman M, Rapp UR
The Journal of biological chemistry 2009 Oct 9;284(41):28004-28020
The Journal of biological chemistry 2009 Oct 9;284(41):28004-28020
Diffuse large B-cell lymphomas with germinal center B-cell-like differentiation immunophenotypic profile are associated with high apoptotic index, high expression of the proapoptotic proteins bax, bak and bid and low expression of the antiapoptotic protein bcl-xl
Maria Bai, Angelos Skyrlas, Niki John Agnantis, Sevasti Kamina, Elena Tsanou, Constantina Grepi, Vassiliki Galani, Panagiotis Kanavaros
Modern Pathology 2004 Apr;17(7):847-856
Modern Pathology 2004 Apr;17(7):847-856
No comments: Submit comment
Supportive validation
- Submitted by
- per
- Main image

- Experimental details
- Western blot analysis of antibody specificity using a routine panel composed of IgG/HSA-depleted human plasma and protein lysates from selected human tissues and cell lines.
- Validation comment
- Single band corresponding to the predicted size in kDa (+/-20%).
- Primary Ab dilution
- 1:500
- Secondary Ab dilution
- 1:7000
- Lane 1
- Marker [kDa]: 230, 110, 82, 49.3, 32.2, 25.5, 17.6
- Lane 2
- RT-4
- Lane 3
- U-251MG sp
- Lane 4
- A-431
- Lane 5
- Liver
- Lane 6
- Testis
- Theoretical target weight
- [kDa] 17
Supportive validation
- Submitted by
- per
- Main image
- Experimental details
- Immunohistochemical staining of human kidney shows strong cytoplasmic positivity in cells in tubules.
- Validation comment
- Staining pattern consistent with experimental and/or bioinformatic data.